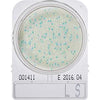
files/compact_dry_ls_507187d5-b92c-4f17-9f4f-86006d79e72b.jpg
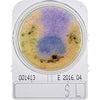
files/compact_dry_sl_8b74a625-e918-47a9-9490-60de15d28dbe.jpg
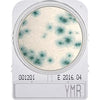
files/ymr100_452ef79c-b087-4b06-a109-51b35493209b.jpg

CompactDry™ Media Specific Plates, Hardy Diagnostics
$258
and up
| Image | SKU | Description | Incubation Time | Incubation Temperature | Extended Information | Quantity | Price | Add to Cart |
|---|---|---|---|---|---|---|---|---|

|
54081 | CompactDry TC, Total Count | 44-48 hrs | 35 °C | For total aerobic viable bacterial count. Growing colonies will appear red. | 240 Pack | $272 | |

|
54082 | CompactDry EC, Escherichia coli and Coliforms | 20-24 hrs. | 35 °C | For the isolation and enumeration of coliforms and E. Coli. Coliform colonies will appear red, and E. coli colonies will appear blue. | 240 Pack | $372 | |
|
LS100 | CompactDry LS, Listeria spp | 24-28 hrs. | 35-37 °C | For the selective growth, presumptive identification, and enumeration of Listeria spp. | 100 Pack | $444 | |
|
54085 | CompactDry SL, Salmonella | 20-24 hrs. | 41-43 °C | For the presumptive identification of Salmonella spp. Growing colonies will appear green or blue-green with black centers. | 240 Pack | $412 | |
|
54084 | CompactDry YMR, Yeast Mold Rapid | 48 hrs | 25 °C | For the isolation and enumeration of yeast and mold. Yeast colonies will appear blue, and molds will form cottony colonies with characteristic colors. | 240 Pack | $432 | |

|
54083 | CompactDry YM, Yeast and Mold | 3-5 days | 25 °C | For the isolation and enumeration of yeast and mold. Yeast colonies will appear blue, and molds will form cottony colonies with characteristic colors. | 240 Pack | $362 | |

|
ETB100 | CompactDry ETB, Enterobacteriaceae | 24-28 hrs. | 35-37 °C | For the isolation and enumeration of organisms belonging to the family Enterobacteriaceae in raw materials, finished products, or on environmental surfaces pertaining to food and related industries. | 100 Pack | $258 |
Description
Simple and Effective System for Colony Counting!
Compact Dry™ is a ready-to-use system reducing the time needed to perform microbial testing on food, beverage, meat, cosmetics, and raw materials. Place 1ml of sample onto the plate and incubate. Colonies grow and develop specific colors from chromogenic substrates. This provides for easy organism differentiation and counting.
Four Easy Steps!
- Remove protective cap from Compact Dry™ plate.
- Drop 1ml of specimen (dilute if necessary) in the middle of dry sheet.
- Specimen diffuses automatically into the plate, transforming the dry medium to gel.
- Re-cap, and incubate for prescribed time. Count the number of colonies on a light box.
Features and Benefits:
- Easy to use
- Sturdy frame, stackable packaging
- Self-diffusing media. No spreader needed.
- Ability to subculture without damage to colonies
- Stored at room temperature vs the competitor products with storage at temperatures less than or equal to 8°C
- No leakage
- Easy to label







